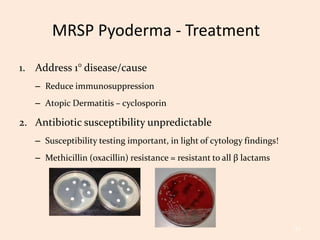

Apoquel immunosuppressant cheap
Apoquel immunosuppressant cheap, Zoetis Apoquel 5.4mg 16mg tablets for dogs LoyalPetZone India cheap
$0 today, followed by 3 monthly payments of $19.33, interest free. Read More
Apoquel immunosuppressant cheap
Zoetis Apoquel 5.4mg 16mg tablets for dogs LoyalPetZone India
Apoquel Chewable 3.6mg Per Chew Prescription Required Your
Apoquel Itching and Skin Inflammation in Dogs VetRxDirect
Zoetis Apoquel 5.4mg 16mg tablets for dogs LoyalPetZone India
Apoquel for Dogs oclacitinib 5.4 mg 60 Tablets Skin
A for Apoquel PPT
ballerinakuchyne.sk
Product code: Apoquel immunosuppressant cheapApoquel Tablet 16mg Per Tablet Prescription Required Your cheap, Agrihealth Animal Health Equipment Wholesaler Veterinary cheap, Apoquel Chewable 16mg per Chew Prescription Required Your cheap, Apoquel Tablets The Veterinary Medicine cheap, Apoquel Tablet cheap, Apoquel For Dogs 5.4 mg cheap, Apoquel for Dogs oclacitinib 16 mg 30 Tablets Skin cheap, Lowest Price Zoetis Apoquel 5.4mg 16mg for dogs 20 tabs 16mg at cheap, A for Apoquel PPT cheap, Apoquel Itching and Skin Inflammation in Dogs VetRxDirect cheap, Agrihealth Animal Health Equipment Wholesaler Veterinary cheap, Buy Zoetis Apoquel for Dogs Online in India Supertails cheap, Apoquel for Dogs oclacitinib 16 mg 30 Tablets Skin cheap, Apoquel Chewable 5.4mg Per Chew Prescription Required Your cheap, Agrihealth Animal Health Equipment Wholesaler Veterinary cheap, Zoetis Apoquel 5.4mg 16mg tablets for dogs LoyalPetZone India cheap, Apoquel Chewable 3.6mg Per Chew Prescription Required Your cheap, Apoquel Itching and Skin Inflammation in Dogs VetRxDirect cheap, Zoetis Apoquel 5.4mg 16mg tablets for dogs LoyalPetZone India cheap, Apoquel for Dogs oclacitinib 5.4 mg 60 Tablets Skin cheap, A for Apoquel PPT cheap, BRINGING AWARENESS TO THE LINK BETWEEN APOQUEL AND CANCER IN DOGS cheap, Apoquel for Dogs oclacitinib 5.4 mg 60 Tablets Skin cheap, A for Apoquel PPT cheap, Apoquel Zoetis Petcare cheap, Apoquel side effects a veterinary dermatologist s experience cheap, Edge Animal Hospital EDGEvet offers both CYTOPOINT and APOQUEL cheap, Buy Apoquel 20 Tabs at a low price in online India on petindiaonline cheap, Apoquel for Dogs Control Itch in 24 Hours Allivet cheap, Lowest Price Zoetis Apoquel 5.4mg 16mg for dogs 20 tabs 16mg at cheap, A for Apoquel PPT cheap, Apoquel Oclacitinib cheap, Zoetis Apoquel 5.4mg 16mg tablets for dogs LoyalPetZone India cheap, Apoquel Apoquel Chewable Zoetis US cheap, Apoquel Safety I Zoetis US cheap, New Treatment Options for Your Dog s Allergies FirstVet cheap, Itching and Scratching Apoquel and Cytopoint may help give relief cheap, Apoquel Oclacitinib Allergy Medicine for Pets Petco cheap, Apoquel Zoetis Petcare cheap, Dog Max Inc Crestview FL cheap, Zoetis Apoquel 5.4mg 16mg tablets for dogs LoyalPetZone India cheap, 5 Apoquel Alternatives for Your Dog ElleVet Sciences cheap, Immunosuppressant Archives The Veterinary Medicine cheap, Cytopoint vs Apoquel For Itchy Pups Mount Pleasant Vet Group cheap, A for Apoquel PPT cheap, Buy Apoquel For Dogs Online cheap, Is Apoquel Helpful or Harmful to Your Dog What Are The cheap, Apoquel oclacitinib tablet I Zoetis US cheap, Apoquel r Shihtzu cheap, Apoquel is an cheap.
-
Next Day Delivery by DPD
Find out more
Order by 9pm (excludes Public holidays)
$11.99
-
Express Delivery - 48 Hours
Find out more
Order by 9pm (excludes Public holidays)
$9.99
-
Standard Delivery $6.99 Find out more
Delivered within 3 - 7 days (excludes Public holidays).
-
Store Delivery $6.99 Find out more
Delivered to your chosen store within 3-7 days
Spend over $400 (excluding delivery charge) to get a $20 voucher to spend in-store -
International Delivery Find out more
International Delivery is available for this product. The cost and delivery time depend on the country.
You can now return your online order in a few easy steps. Select your preferred tracked returns service. We have print at home, paperless and collection options available.
You have 28 days to return your order from the date it’s delivered. Exclusions apply.
View our full Returns and Exchanges information.
Our extended Christmas returns policy runs from 28th October until 5th January 2025, all items purchased online during this time can be returned for a full refund.
Find similar items here:
Apoquel immunosuppressant cheap
- apoquel immunosuppressant
- apoquel immune system
- apoquel human equivalent
- apoquel in cats
- apoquel information
- apoquel ingredients
- apoquel injection for dogs
- apoquel label
- apoquel itch relief for dogs
- apoquel lethargy